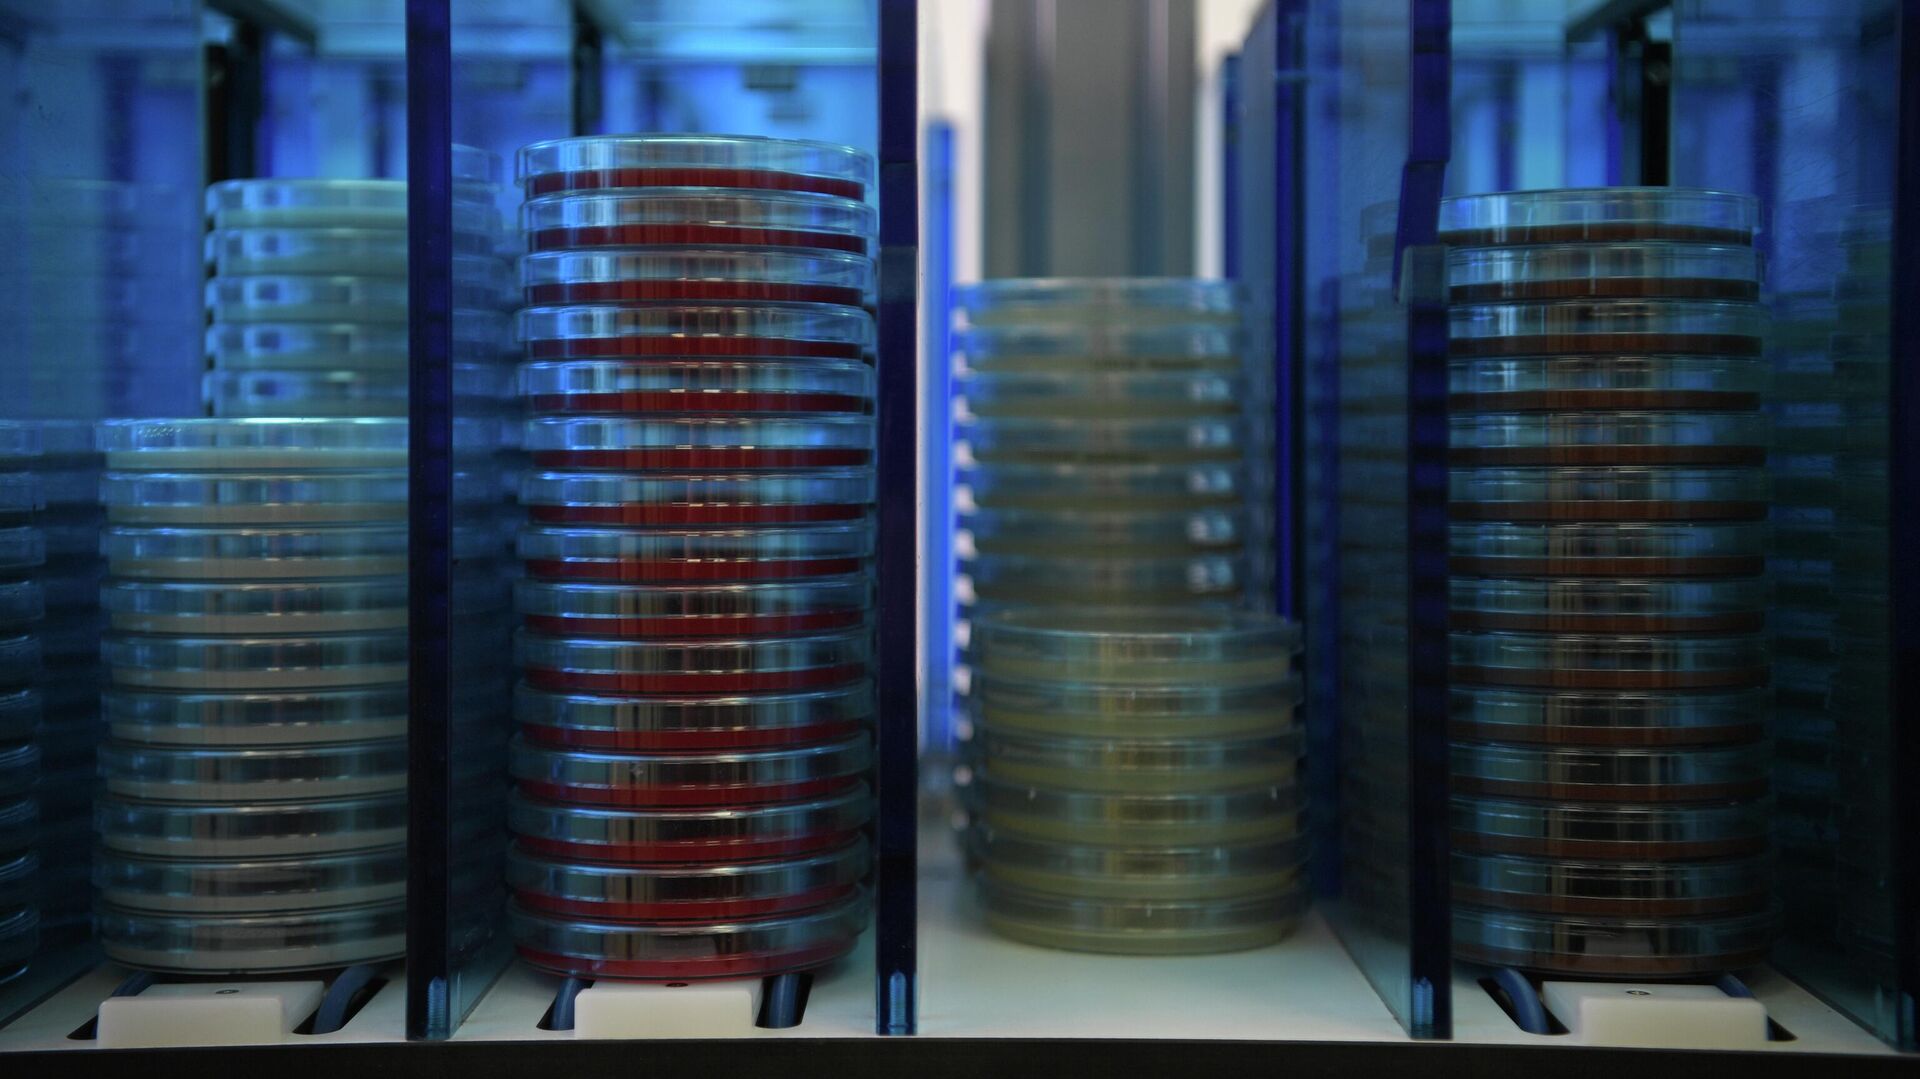

https://sputnik.by/20251204/test-dlya-bystrogo-vyyavleniya-vozbuditelya-tyazhelykh-infektsiy-razrabotali-v-rossii-1102254205.html
Тест для быстрого выявления возбудителя тяжелых инфекций разработали в России
Тест для быстрого выявления возбудителя тяжелых инфекций разработали в России
Sputnik Беларусь
Новый метод лабораторного исследования обладает высокой чувствительностью, сопоставимой с ПЦР-диагностикой, но в разы быстрее. 04.12.2025, Sputnik Беларусь
2025-12-04T16:03+0300
2025-12-04T16:03+0300
2025-12-04T16:43+0300
россия
здоровье
наука и технологии
роспотребнадзор
https://cdnn11.img.sputnik.by/img/07e9/0c/04/1102253607_0:320:3072:2048_1920x0_80_0_0_e6beefd4d5a6b275f8437433d1320453.jpg
МИНСК, 4 дек – Sputnik. Высокочувствительный тест для быстрого обнаружения бактерии Klebsiella pneumoniae разработали специалисты Центрального научно-исследовательского института эпидемиологии Роспотребнадзора, сообщили в ведомстве.Уточняется, что специалисты занимались разработкой нового метода лабораторных исследований в рамках федерального проекта "Санитарный щит страны – безопасность для здоровья".Тест обладает высокой чувствительностью, сопоставимой с ПЦР-диагностикой. При этом у него есть существенное преимущество. В отличие от метода полимеразной цепной реакции, при использовании которого результатов нужно ждать от нескольких часов до нескольких суток, новый тест позволяет обнаружить опасный патоген всего за полчаса.Преимущества нового метода лабораторных исследований позволяют начать лечение своевременно с использованием именно тех антибактериальных препаратов, которые дадут быстрый и высокий терапевтический эффект, что критически важно для спасения жизней пациентов.Klebsiella pneumoniaeKlebsiella pneumoniae (клебсиелла пневмонии) – это распространенная условно - патогенная бактерия, которая встречается повсеместно в окружающей среде. В организме человека она обитает преимущественно в толстом кишечнике, но также встречается в здоровой микрофлоре рта и кожи.Особую опасность Klebsiella pneumoniae представляет для людей с незрелым или ослабленным иммунитетом.Опасность патогена в том, что он может стать причиной тяжелых инфекционных заболеваний: бактериальных пневмоний, инфекций мочевыводящий путей, менингита, сепсиса. Кроме того, Klebsiella pneumoniae – один из главных возбудителей внутрибольничных инфекций.Основная проблема заключается в сложности лечения заболеваний, вызванных этой бактерией.Клетки клебсиеллы пневмонии окружены толстой капсулой, при этом формируют биопленки и вырабатывают ферменты, которые нейтрализуют действие антибиотиков, уточнили в Роспотребнадзоре. Это создает определенный дефицит доступных способов лечения инфекций. Среди штаммов Klebsiella pneumoniae известны супербактерии, устойчивые практически ко всем существующим в настоящее время антибактериальным препаратам.Самые интересные и важные новости ищите в нашем Telegram-канале и Viber. Также следите за нами в Дзен!
россия
Sputnik Беларусь
media@sputniknews.com
+74956456601
MIA „Rossiya Segodnya“
2025
Sputnik Беларусь
media@sputniknews.com
+74956456601
MIA „Rossiya Segodnya“
Новости
ru_BY
Sputnik Беларусь
media@sputniknews.com
+74956456601
MIA „Rossiya Segodnya“
Sputnik Беларусь
media@sputniknews.com
+74956456601
MIA „Rossiya Segodnya“
россия, здоровье , наука и технологии, роспотребнадзор
россия, здоровье , наука и технологии, роспотребнадзор
Тест для быстрого выявления возбудителя тяжелых инфекций разработали в России
16:03 04.12.2025 (обновлено: 16:43 04.12.2025) Новый метод лабораторного исследования обладает высокой чувствительностью, сопоставимой с ПЦР-диагностикой, но в разы быстрее.
МИНСК, 4 дек – Sputnik. Высокочувствительный тест для быстрого обнаружения бактерии Klebsiella pneumoniae разработали специалисты Центрального научно-исследовательского института эпидемиологии Роспотребнадзора, сообщили в ведомстве.
"Специалисты ФБУН ЦНИИ эпидемиологии Роспотребнадзора разработали эффективный тест для диагностики Klebsiella pneumoniae с использованием метода петлевой изотермической амплификации (LAMP)", – говорится в сообщении, опубликованном в Telegram-канале ведомства.
Уточняется, что специалисты занимались разработкой нового метода лабораторных исследований в рамках федерального проекта "Санитарный щит страны – безопасность для здоровья".
Тест обладает высокой чувствительностью, сопоставимой с ПЦР-диагностикой. При этом у него есть существенное преимущество. В отличие от метода полимеразной цепной реакции, при использовании которого результатов нужно ждать от нескольких часов до нескольких суток, новый тест позволяет обнаружить опасный патоген всего за полчаса.
"Результат анализа образца можно получить всего за 30 минут, что значительно быстрее, чем при использовании ПЦР", – сообщили специалисты.
Преимущества нового метода лабораторных исследований позволяют начать лечение своевременно с использованием именно тех антибактериальных препаратов, которые дадут быстрый и высокий терапевтический эффект, что критически важно для спасения жизней пациентов.
Klebsiella pneumoniae (клебсиелла пневмонии) – это распространенная условно - патогенная бактерия, которая встречается повсеместно в окружающей среде. В организме человека она обитает преимущественно в толстом кишечнике, но также встречается в здоровой микрофлоре рта и кожи.
Особую опасность Klebsiella pneumoniae представляет для людей с незрелым или ослабленным иммунитетом.
Опасность патогена в том, что он может стать причиной тяжелых инфекционных заболеваний: бактериальных пневмоний, инфекций мочевыводящий путей, менингита, сепсиса. Кроме того, Klebsiella pneumoniae – один из главных возбудителей внутрибольничных инфекций.
Основная проблема заключается в сложности лечения заболеваний, вызванных этой бактерией.
Клетки клебсиеллы пневмонии окружены толстой капсулой, при этом формируют биопленки и вырабатывают ферменты, которые нейтрализуют действие антибиотиков, уточнили в Роспотребнадзоре. Это создает определенный дефицит доступных способов лечения инфекций. Среди штаммов Klebsiella pneumoniae известны супербактерии, устойчивые практически ко всем существующим в настоящее время антибактериальным препаратам.
Самые интересные и важные новости ищите в нашем Telegram-канале и Viber. Также следите за нами в Дзен!